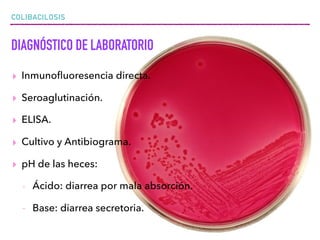
COLIBACILOSIS
DIAGNÓSTICO DE LABORATORIO
▸ Inmunoﬂuoresencia directa.
▸ Seroaglutinación.
▸ ELISA.
▸ Cultivo y Antibiograma.
▸ pH de las heces:
- Ácido: diarrea por mala absorción.
- Base: diarrea secretoria.

La colibacilosis es una enfermedad causada por la bacteria Escherichia coli que puede afectar diversos animales como cerdos, humanos, bovinos y aves. Provoca diarrea, deshidratación y en ocasiones la muerte. Se transmite por la vía fecal-oral y su prevención incluye medidas de higiene, cocción de alimentos y vacunación.